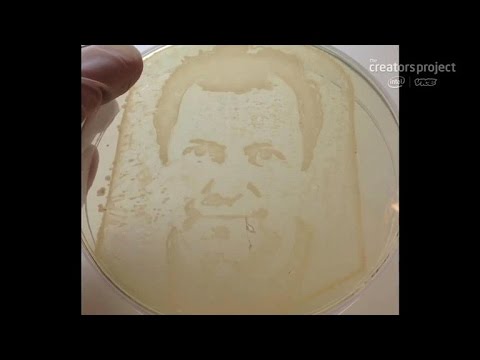
Crave - Science and art team up to create cancer cell and bacteria portraits, Ep. 174 - UCOmcA3f_RrH6b9NmcNa4tdg

CNET - Channel
-
CNET How To - Using the People Edge on the Samsung Galaxy S6 Edge
The curved screen of the S6 Edge gives you quick access to your five favorite contacts. -
The Fix - Turn a dumb car into a smart one
Check out a free app for Android and iOS that connects to your car so you can track your driving... -
Apple Byte - Google aims directly at Apple
Google I/O 2013 showcases updates to Google Maps, Google Now, and Hangouts that will all be on i... -
Watch out... the Shark Rotator Pro Lift-Away is coming for you
This vacuum competes comfortably with more expensive models. -
The Fix - A simple DIY smartphone mount
Need to mount your smartphone in your car in a pinch? Donald Bell has a DIY solution that takes ... -
CNET Update - Breaking open iPads, Groupon's quest to be Yelp
The iFixit team reveals the secrets inside the new iPads, Groupon mimics Yelp, and Microsoft kil... -
Tomorrow Daily - 029: A morphing toy robot, the Polaris Slingshot, GIF street art, and more
On today's show, we check out a toymaker's cool robot creation, a slick new trike vehicle from P... -
Apple Byte - What to expect at Apple's October 22nd event
We'll break down everything we expect to see from Apple next week including new iPads, MacBook P... -
Crave - Science and art team up to create cancer cell and bacteria portraits, Ep. 174
Link to all the links - This week on Crave we check out a light-based Rube Goldberg machine com... -
CNET Update - Candy-colored iPhone photos surface online
More reports are out about Apple's cheaper iPhone, Best Buy will sell the popular Pebble smartwa... -
CNET Update - Free iOS apps during App Store anniversary
Some popular iTunes apps and games are free, Garmin's new device projects directions onto the wi... -
CNET News - Drones take center stage at the first ever Silicon Valley Fashion Show
Tech meets fashion at the one of a kind Silicon Valley Fashion Show where drones became models fo...